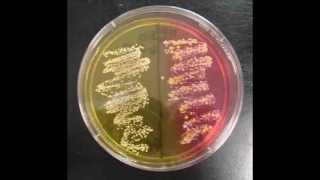

Huidmicrobioom
Mannitol-zoutagar test

Infectieziekten

Wat is een urineweginfectie?

Dipslide test
-
Huidmicrobioom
Uitlegvideo over de bacteriën die op de huid groeien -
Mannitol-zoutagar test
In deze uitlegvideo wordt de selectie van stapylococcen op mannitol zout agar gedemonstreerd. -
Infectieziekten
Uitlegvideo over infectieziekten. -
Wat is een urineweginfectie?
Uitlegvideo over de blaasontsteking. -
Dipslide test
In deze uitlegvideo wordt de dipslide test gedemonstreerd.

